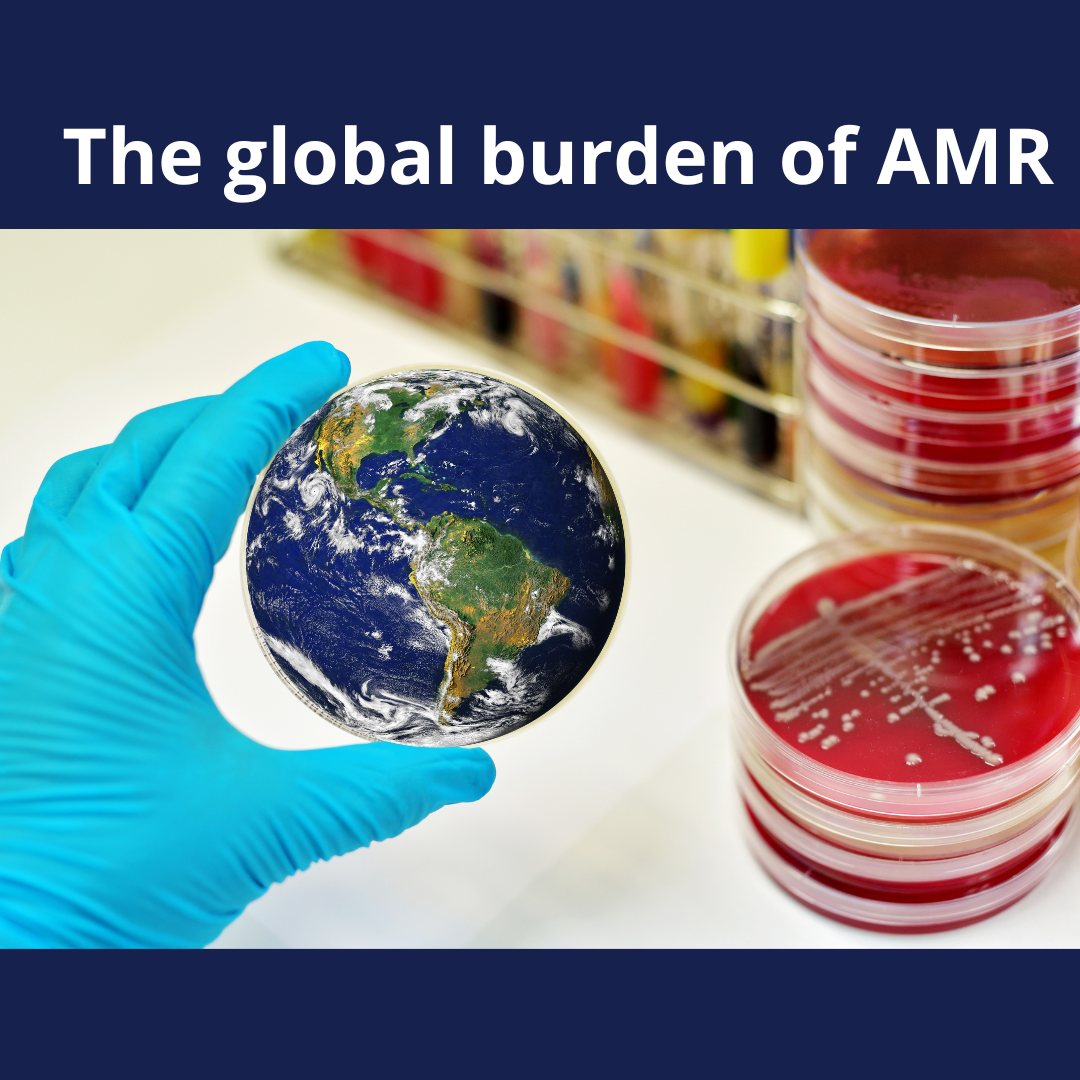

Latest News
Filter by:
Blog

Do clients really want antibiotics?
10 Oct 2022
Are we making assumptions about clients that are not entirely true?
Read more

What's so hard about AMS?
15 Sep 2022
This post explores barriers to implementation of AMS
Read more
The global burden of AMR
12 Aug 2022
Global estimates to help us look at the big picture
Read more

A tale of hedgehogs and AMR...
01 Jun 2022
How hedgehogs can teach us a thing or two about antimicrobial resistance
Read more

Heuristics!
19 Apr 2022
A deep dive into how we think about diagnoses - the use of heuristics in clinical reasoning
Read more
Podcasts
ABC of AMS in wildlife episode 2 - caring for paediatric mammals (for CARERS) with Michelle Ward
09 Dec 2025
In this episode we speak with Dr Michelle Campbell-Ward about caring for paediatric mammals - this episode is specifically tailored for wildlife carers.
Listen here
ABC of AMS in wildlife episode 1 - The story behind the wildlife guidelines with Simone Vitali
19 Nov 2025
This podcast episode is the first in our 'ABC of AMS in wildlife' series. We talk to Simone Vitali about the background to the development of the Antimicrobial Prescribing Guidelines for Australian Wildlife.
Listen here
Ep 10 - Infection Prevention and Control
08 Sep 2022
Dr Angela Willemsen discussed Infection Prevention and Control - including how to get a plan in place for your clinic. Follow the link for additional resources.
Listen here
Ep 9 - Antibiotic dose rates - how to get them right
19 Aug 2022
This podcast discusses antibiotic dose rates and frequencies. Resources can be found at: vetantibiotics.fvas.unimelb.edu.au/ www.amrvetcollective.com/guidelines. Contact for resources and feedback: vet-antibiotics@umelb.edu.au
Listen here
Ep 8 - The Poultry Module!
04 Aug 2022
Drs Rod Jenner and Jo Coombe discuss the first species-specific module on www.vetams.org - the Poultry Module!
Listen here
